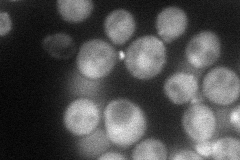
YER008C
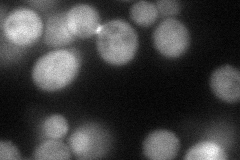
YER008C
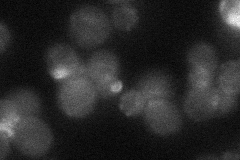
YER008C
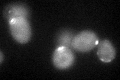
YER008C

View description
Subunit of the exocyst complex (Sec3p, Sec5p, Sec6p, Sec8p, Sec10p, Sec15p, Exo70p, Exo84p) which mediates targeting of post-Golgi vesicles to sites of active exocytosis; Sec3p specifically is a spatial landmark for secretion
Localization:
Intensity:
Fold change:
Significance:
-
C’ GFP library in SD

bud neck -
N' NOP1pr-GFP in SD
cytosol,bud52.319 -
N' TEF2pr-mCherry in SD
bud neck54.2674 -
N' NATIVEpr-GFP in SD
bud neck21.9895 -
N' TEF2pr-VC and Cyto-VN in SD

cytosol36.0902 -
C’ GFP library in SD+DTT
bud neck31.010.98No -
C’ GFP library in SD+H2O2

cytosolN/AN/ANo -
C’ GFP library in Starvation Media

punctateN/AN/AYes -
C’ GFP library on the background of Pup2-DaMP

bud neck -
C’ GFP library on the background of CCT mutant

bud neck25.91860.821693No
